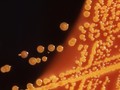
Ảnh minh họa

|
|
Các chuyên gia chia sẻ về kháng thuốc kháng sinh tại buổi họp báo trước thềm lễ mít tinh (Ảnh: Minh Thúy)
|
Thuốc kháng sinh mang lại nhiều lợi ích to lớn: Giảm tỷ lệ tử vong và các biến chứng của các bệnh nhiễm khuẩn; khống chế nhiều dịch bệnh gồm dịch hạch, dịch tả…
Tuy nhiên, việc sử dụng thuốc kháng sinh không hợp lý đang làm gia tăng các trường hợp kháng thuốc, khiến nhiều bệnh nhân bị nhiễm trùng nặng khó điều trị; gây ngộ độc, dị ứng, loạn khuẩn... làm nặng thêm bệnh, nguy cơ tử vong cao.
Theo PGS.TS. Lương Ngọc Khuê, sau 5 năm thực hiện kiểm soát chặt, hiện nay tỷ lệ bác sĩ, cơ sở y tế kê đơn kháng sinh bừa bãi, sử dụng thuốc sai nguyên tắc đã giảm; hàng ngàn bác sĩ, dược sĩ cam kết không sử dụng thuốc kháng sinh sai nguyên tắc.
Song, khi chấn chỉnh được việc kê đơn trong bệnh viện, thì hệ thống cửa hàng thuốc vẫn chưa quản lý chặt việc bán thuốc kháng sinh nên ở nhiều nơi, thuốc kháng sinh được bán dễ dàng mà không cần đơn thuốc, khiến cho việc lạm dụng vẫn phổ biến
“Ra hiệu thuốc để quan sát, tôi thấy có người chỉ kể vài triệu chứng là được nhà thuốc kê đơn, bán cho thuốc kháng sinh” – PGS.TS. Lương Ngọc Khuê nói.
Đồng quan điểm trên, GS.TS. Ngô Quý Châu – Phó Giám đốc Phụ trách Bệnh viện Bạch Mai - cũng cho biết, nhiều bệnh nhân chỉ mới chớm ho, hơi sốt, thì ngay lập tức đi mua thuốc về uống, mà không cần thăm khám; có bệnh nhân được bác sĩ kê đơn, rồi khi bệnh tái phát, họ đi mua lại theo đơn thuốc cũ.
“Vì người dân tự mua thuốc kháng sinh, sử dụng không đúng, nên thuốc không phù hợp với tình trạng bệnh, đặc biệt là liều lượng sử dụng. Ví dụ, có thuốc phải dùng tới 3g/ngày, nhưng người dân tự uống chỉ dùng 1,5g/ngày” – GS.TS. Ngô Quý Châu nói.
Hậu quả, khi sử dụng thuốc kháng sinh không đủ liều, vi khuẩn sẽ thích nghi với thuốc kháng sinh đó, thay vì bị tiêu diệt, đồng thời làm yếu sức đề kháng của cơ thể. Một số bệnh nhân tự dùng thuốc trong 2 - 3 ngày, khi thấy đỡ thì bỏ thuốc, làm lan tràn vi khuẩn kháng thuốc do kháng sinh không đủ liều lượng để diệt hết vi khuẩn.
GS.TS. Ngô Quý Châu cũng cho biết, đối với các bệnh nhân mắc nhiều bệnh, việc sử dụng thuốc kháng sinh không phù hợp dẫn tới không khỏi bệnh, không thể hấp thu thuốc và nhiều tác dụng không mong muốn khác.
 |
|
PGS.TS. Lương Ngọc Khuê - Cục trưởng Cục Quản lý Khám, chữa bệnh phát biểu khai mạc buổi lễ mít tinh (Ảnh: Minh Thúy).
|
Bên cạnh đó, TS. Kidong Park - Trưởng đại diện Văn phòng WHO tại Việt Nam - cho biết, nếu không hành động ngay từ hôm nay, kháng thuốc sẽ gây ra hệ lụy là từ nay đến năm 2050 có trên 10 triệu ca tử vong mỗi năm, cao hơn số ca tử vong vì ung thư. Kháng thuốc tạo gánh nặng kinh tế toàn cầu, tiêu tốn khoảng 100 tỷ USD, đồng thời, từ nay đến năm 2030, 24 triệu người sẽ rơi vào tình trạng đói nghèo.
Ông Kidong Park cũng cho biết, tình hình kháng thuốc của Việt Nam sẽ trở nên báo động, bởi Việt Nam đứng thứ 11 trong những quốc gia có tần suất sử dụng kháng sinh nhiều nhất.
“Để giảm tỷ lệ kháng thuốc, ngay từ bây giờ, phải cùng nhau giảm thiểu nhất có thể việc sử dụng kháng sinh không cần thiết” - TS. Kidong Park khuyến cáo.
Vì vậy, Bộ Y tế tiếp tục cùng Ban Chỉ đạo Quốc gia về phòng, chống kháng thuốc và các đối tác quốc tế bao gồm Tổ chức Y tế Thế giới (WHO) và Tổ chức Nông lương Thế giới (FAO), kêu gọi cộng đồng cùng nỗ lực phòng chống kháng thuốc.
Ông Kidong Park cho biết thêm, Tổng hội Y học Việt Nam đã trở thành đối tác mới của WHO trong việc giáo dục và khuyến khích bác sĩ và dược sĩ sử dụng kháng sinh hợp lý. WHO và Tổ chức FAQ cũng ra tuyên bố chung để khẳng định cam kết sẽ tiếp tục hỗ trợ Việt Nam phòng, chống kháng thuốc kháng sinh trong tương lai.
PGS.TS. Lương Ngọc Khuê mong muốn người bệnh, thầy thuốc, các cơ sở khám chữa bệnh, các cơ quan quản lý, không chỉ ngành y tế mà các bộ ngành liên quan, cùng chung tay thực hiện cam kết không lạm dụng, không sử dụng thuốc kháng sinh sai chỉ định, để đẩy lùi nguy cơ kháng thuốc, cứu sống người bệnh.